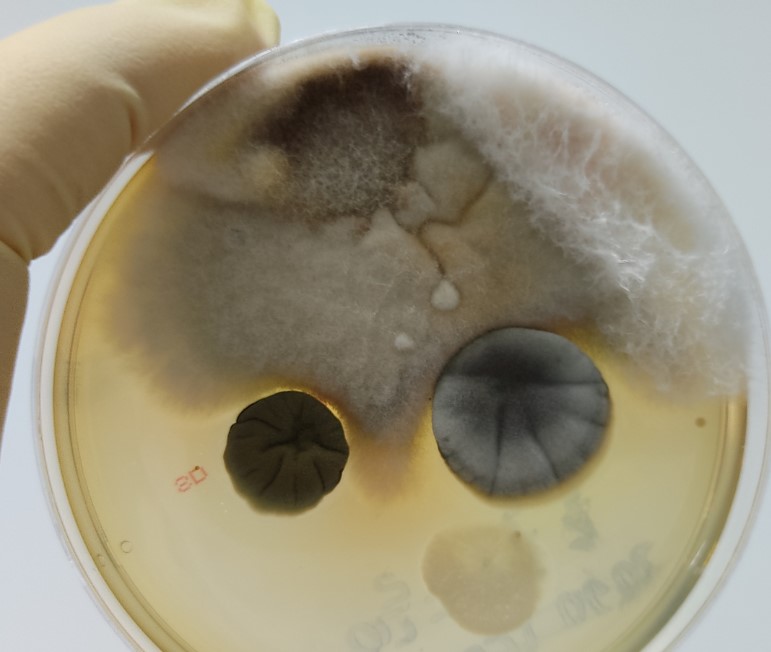
Mold in tube

Mold is a fungus that thrives in moist environments, growing on various surfaces, such as walls, ceilings, carpets, and furniture. Mold spores are microscopic and can easily spread through the air, making them challenging to detect without proper inspection. These spores can latch onto any organic matter, and given the right conditions, they can proliferate rapidly, spreading across large areas of your property. The presence of mold not only affects aesthetics but also compromises the structural integrity of buildings by gradually breaking down materials.
Why Mold is a Problem
Mold can cause health issues like breathing problems, allergic reactions, and other health complications. For businesses, mold can lead to expensive repairs, legal liabilities, and a negative impact on employee productivity due to health-related absences. The health implications can be severe, especially for individuals with pre-existing conditions such as asthma or weakened immune systems. Furthermore, mold can tarnish a company’s reputation, leading to a loss of business if customers or clients perceive the property as unsafe or poorly maintained.
Common Causes of Mold
Mold growth is often the result of water damage, which can be caused by leaks, floods, or high humidity levels. Poor ventilation and inadequate maintenance can also contribute to mold problems in commercial properties. In areas with high rainfall or humidity, mold can become a perennial issue if not properly managed.
Additionally, construction flaws, such as improper sealing of windows and doors or insufficient drainage systems, can exacerbate moisture problems. Regular inspection and maintenance are crucial in identifying and resolving these issues before they lead to significant mold growth.
Identifying Mold in Commercial Properties
Early detection of mold is crucial to prevent extensive damage and health risks. Here are some signs to look for:
Visible Signs
One of the most obvious signs of mold is visible growth on surfaces. Mold can appear in various colors, including black, green, white, or orange, and often looks like spots or patches. These growths can vary in texture and size, ranging from small dots to large patches that cover entire walls or ceilings. It’s important to regularly check areas that are prone to moisture, such as bathrooms, kitchens, and basements, as mold can thrive in these environments unnoticed until it becomes a significant issue.
Musty Odor
Mold often produces a distinctive musty smell. If you notice an unusual odor in your building, it could be an indication of hidden mold growth. This smell is often more pronounced in enclosed spaces or areas with poor ventilation.
Regularly walking through different parts of your property and paying attention to any changes in odor can help in early detection. If the smell persists despite cleaning and ventilation efforts, it’s advisable to conduct a thorough inspection for mold.
Health Symptoms
If occupants are experiencing unexplained health issues such as sneezing, coughing, or skin irritation, it might be due to mold exposure. These symptoms can often be mistaken for common colds or allergies, prolonging exposure and exacerbating health issues. It’s important to consider mold as a potential cause if multiple occupants report similar symptoms, especially if they improve when away from the property. Ensuring open communication with employees about indoor air quality concerns can aid in early detection.
Mold Inspection and Testing
To accurately identify mold and assess the extent of the problem, professional mold inspection services are recommended. These experts use specialized equipment to detect mold presence and determine the severity of contamination. Engaging professionals helps ensure that mold issues are not only identified but also properly documented, which is crucial for remediation planning and any potential legal considerations.
Professional Mold Inspection
A professional mold inspection involves a thorough examination of the property, including areas that are often overlooked, such as HVAC systems, attics, and crawl spaces. Inspectors may also collect air samples to analyze the concentration of mold spores. This approach allows for the detection of mold in hidden or hard-to-reach areas, ensuring that all potential sources of contamination are addressed. Professional inspectors can also provide guidance on preventive measures to avoid future mold issues.
Mold Testing
Mold testing can help identify the type of mold present and guide the remediation process. Various testing methods include air sampling, surface sampling, and bulk sampling. Each method provides different insights into the mold situation, from the types and concentrations of spores in the air to the extent of contamination on surfaces. Understanding the specific type of mold can inform the choice of cleaning agents and remediation techniques, making the process more effective and tailored to the situation.
Addressing Mold Issues
Once the mold is identified, it’s crucial to take prompt action to remove it and prevent future growth. Delayed remediation can lead to further damage and increased health risks, making it essential to act swiftly and decisively.
Mold Remediation Process
Mold remediation involves several steps to ensure complete removal and prevent recurrence:
- Containment: Isolate the affected area to prevent the spread of mold spores to other parts of the building. This often involves sealing off the area with plastic sheeting and using negative air pressure to contain spores.
- Air Filtration: Use air scrubbers and HEPA vacuums to capture mold spores in the air. High-efficiency particulate Air (HEPA) filters are effective in removing even the smallest spores, improving air quality during and after remediation.
- Removal: Remove and dispose of contaminated materials, such as drywall, insulation, and carpeting. This step is crucial in eliminating sources of mold growth and may require the replacement of severely affected materials.
- Cleaning: Clean and disinfect affected surfaces with mold-specific cleaning agents. Specialized cleaning products not only remove existing mold but also inhibit future growth, providing a layer of protection.
- Restoration: Repair and restore the damaged areas to their original condition. This may include repainting, replacing fixtures, or other repairs necessary to restore the property’s appearance and functionality.
Hiring a Mold Restoration Company
For effective mold remediation, hire a professional mold restoration company, like us here at The Healthy Environments. These experts have the tools, experience, and knowledge to handle mold problems safely and efficiently. They can provide comprehensive solutions tailored to your property’s specific needs, ensuring that all aspects of the mold issue are addressed. Partnering with a reputable company also offers peace of mind, knowing that the remediation process is in capable hands and that preventive measures are in place to avoid future outbreaks.
Preventing Future Mold Growth

Prevention is key to avoiding mold issues in the future. Here are some steps to take:
Improve Ventilation
Ensure proper ventilation, especially in high-moisture zones like bathrooms and kitchens. This helps reduce humidity levels and prevents mold growth. Consider installing exhaust fans or upgrading existing ventilation systems to improve airflow. Regularly cleaning vents and ensuring they are unobstructed can also enhance their effectiveness in reducing moisture accumulation.
Regular Maintenance
Conduct regular maintenance checks to identify and repair leaks or water damage promptly. Inspect HVAC systems and clean them regularly to prevent mold buildup. Routine inspections can help catch minor issues before they escalate into major problems, saving time and money in the long run. Additionally, maintaining a log of maintenance activities can help track patterns and identify recurring issues that may need more comprehensive solutions.
Monitor Humidity Levels
Use dehumidifiers to maintain indoor humidity levels below 60%. Installing humidity monitors can help keep track of moisture levels in the building. These devices provide real-time data, allowing for quick adjustments to environmental controls if needed. By keeping humidity in check, you create an inhospitable environment for mold, reducing the likelihood of growth.
Conclusion
Mold is a serious issue that can have significant impacts on commercial properties and their occupants. By understanding how to identify and address mold problems, you can protect your property and ensure a healthy environment for everyone. Remember, early detection and professional remediation are crucial to effectively handling mold issues. Investing in preventive measures and regular maintenance will reduce the risk of future mold problems and enhance the overall value of your property.
With the right approach, you can prevent mold from becoming a recurring problem in your commercial property. Taking these steps not only protects your investment but also demonstrates a commitment to health and safety, fostering a positive and productive workplace environment.
For expert mold inspection and remediation services in Tallahassee, contact The Healthy Environments today!
